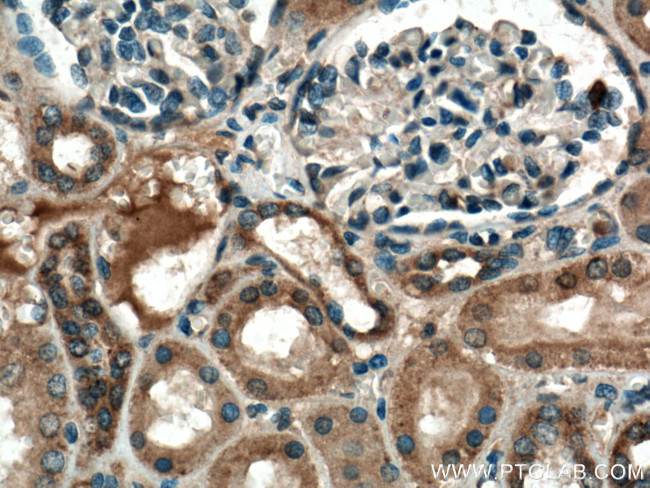
RAB7A Antibody in Immunohistochemistry (Paraffin) (IHC (P))
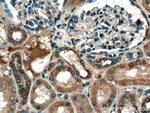
RAB7A Antibody in Immunohistochemistry (Paraffin) (IHC (P))

Search
Proteintech
RAB7A Polyclonal Antibody
{{$productOrderCtrl.translations['antibody.pdp.commerceCard.promotion.promotions']}}
{{$productOrderCtrl.translations['antibody.pdp.commerceCard.promotion.viewpromo']}}
{{$productOrderCtrl.translations['antibody.pdp.commerceCard.promotion.promocode']}}: {{promo.promoCode}} {{promo.promoTitle}} {{promo.promoDescription}}. {{$productOrderCtrl.translations['antibody.pdp.commerceCard.promotion.learnmore']}}
产品信息
55469-1-AP
种属反应
已发表种属
宿主/亚型
分类
类型
抗原
偶联物
形式
浓度
规格
纯化类型
保存液
内含物
保存条件
运输条件
产品详细信息
This antibody is specific to RAB7A.
靶标信息
RAB family members are small, RAS-related GTP-binding proteins that are important regulators of vesicular transport. Each RAB protein targets multiple proteins that act in exocytic / endocytic pathways. This gene encodes a RAB family member that regulates vesicle traffic in the late endosomes and also from late endosomes to lysosomes. This encoded protein is also involved in the cellular vacuolation of the VacA cytotoxin of Helicobacter pylori. Mutations at highly conserved amino acid residues in this gene have caused some forms of Charcot-Marie-Tooth (CMT) type 2 neuropathies.
仅用于科研。不用于诊断过程。未经明确授权不得转售。
生物信息学
蛋白别名: rab-7; RAB7, member RAS oncogene family; Ras-associated protein RAB7; Ras-related protein BRL-RAS; Ras-related protein p23; Ras-related protein Rab-7a; unnamed protein product
基因别名: CMT2B; PRO2706; RAB7; RAB7A
UniProt ID: (Human) P51149, (Mouse) P51150, (Rat) P09527
Entrez Gene ID: (Human) 7879, (Mouse) 19349, (Rat) 29448